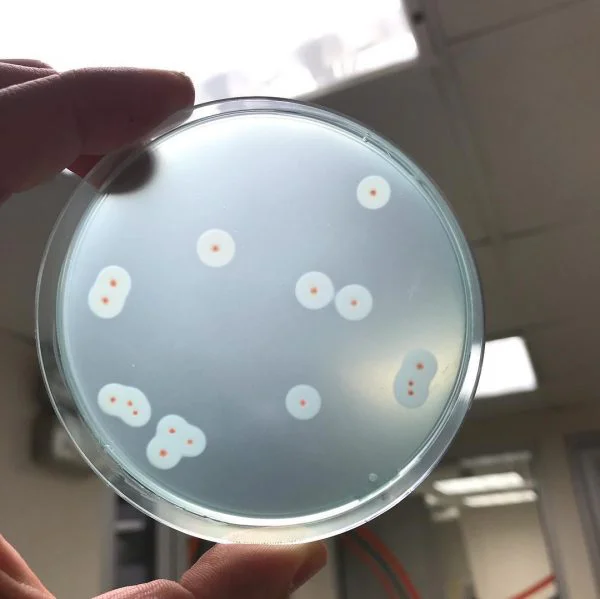
محیط کشت اکسیداز آگار
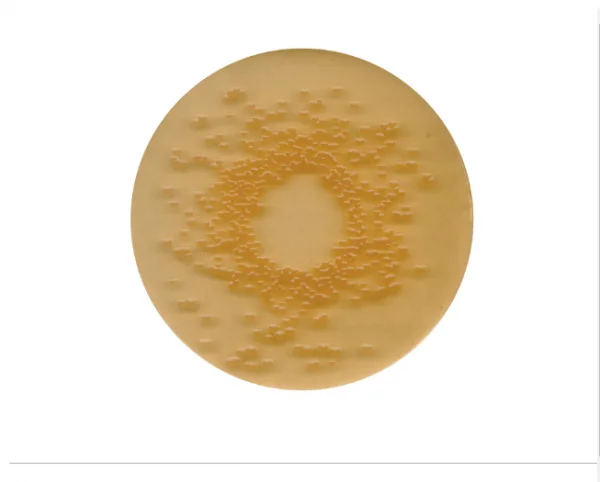
محیط کشت DEV ژلاتین

تجهیزات آزمایشگاهی
با طیف وسیعی از تجهیزات آزمایشگاهی ما قدم به دنیای علم بگذارید! از لولههای آزمایش گرفته تا میکروسکوپ، ما همه چیزهایی را که برای آزمایشها و آنالیزهای شما نیاز دارید، در اختیار داریم. منتخب تجهیزات باکیفیت ما را از برندهای مورد اعتماد که برای برآوردن نیازها و مشخصات آزمایشگاه شما طراحی شده اند، کشف کنید. محصولات ما شامل ظروف شیشه ای آزمایشگاهی، مواد شیمیایی، تجهیزات ایمنی، ترازو، ترازو، پیپت، مبلمان آزمایشگاهی و موارد دیگر می باشد. زیرساخت آزمایشگاه خود را با تجهیزات حرفه ای ما ارتقا دهید و آزمایشات خود را دقیق، دقیق و کارآمد کنید. اکنون خرید کنید و توانایی های تحقیقات علمی خود را افزایش دهید.
انواع تجهیزات آزمایشگاهی
مجموعه تجهیزات آزمایشگاهی آریاطب را برای تمام نیازهای علمی خود جستجو کنید. از میکروسکوپ گرفته تا سانتریفیوژ، ما همه چیزهایی را که برای انجام آزمایشها و آنالیزهای دقیق نیاز دارید، در اختیار داریم. تجهیزات آزمایشگاهی ما از تولید کنندگان برتر تهیه شده و برای مطابقت با بالاترین استانداردهای صنعتی طراحی شده اند.
میکروسکوپ ها: با طیف وسیعی از میکروسکوپ های پیشرفته ما جهان را با جزئیات میکروسکوپی کشف کنید. ایده آل برای مطالعه نمونه های بیولوژیکی، میکروارگانیسم ها و موارد دیگر.
لوله های آزمایش و فلاسک: ظروف شیشه ای با کیفیت برای اندازه گیری های دقیق و واکنش های بدون آلودگی.
مشعلهای Bunsen و تجهیزات گرمایشی: از لیوانهای ساده گرفته تا مانتوهای گرمایشی پیچیده، ما همه چیز برای گرم کردن آزمایشهای شما داریم.
پیپت ها و قطره چکان ها: مقادیر دقیقی از مایعات را برای آزمایش هایی که نیاز به دقت و قوام دارند توزیع کنید.
سانتریفیوژها: مخلوطها را بر اساس چگالی جدا میکنند و امکان تجزیه و تحلیل بیشتر اجزا را فراهم میکنند.
ترازو و ترازو: نمونه ها را با تجهیزات توزین با کیفیت بالا به دقت اندازه گیری و وزن کنید.
با تجهیزات آزمایشگاهی ما می توانید هر آزمایشی را با دقت، دقت و اطمینان انجام دهید. مجموعه ما را برای یافتن تجهیزات مناسب برای نیازهای آزمایشگاهی خود مرور کنید.

خرید تجهیزات آزمایشگاهی
به بخش تجهیزات آزمایشگاهی ما خوش آمدید! در اینجا همه چیزهایی را که برای تجهیز آزمایشگاه خود نیاز دارید، پیدا خواهید کرد، چه یک محقق حرفه ای باشید و چه دانش آموزی که در حال انجام آزمایشات هستید.
ما طیف گسترده ای از تجهیزات آزمایشگاهی با کیفیت بالا را ارائه می دهیم که شامل میکروسکوپ، سانتریفیوژ، تعادل، پیپت، لیوان، فلاسک، لوله آزمایش، دستگاه PCR، صفحه داغ، همزن، اسپکتروفتومتر و غیره می شود. تجهیزات انتخابی ما از برندهای مورد اعتماد در صنعت تهیه شده است و به گونه ای طراحی شده است که کار شما در آزمایشگاه را دقیق، دقیق و کارآمد کند.
ما همچنین یک تیم آگاه و با تجربه داریم که به شما کمک می کند تا بهترین تجهیزات را برای نیازهای خود انتخاب کنید. هدف ما ارائه تجهیزات قابل اعتماد و بادوام است که تمام نیازهای آزمایشگاهی شما را برآورده کند. بنابراین، امروز انتخاب ما را مرور کنید و تجهیزات مورد نیاز خود را برای انجام آزمایشهای پیشگامانه بیابید.

خرید و فروش تجهیزات آزمایشگاهی
تجهیزات آزمایشگاهی، مجموعهای از ابزارها و وسایل هستند که برای انجام آزمایشها، تحقیقات و مطالعات علمی مورد استفاده قرار میگیرند. این تجهیزات به دانشمندان، پژوهشگران و تکنسینهای آزمایشگاه کمک میکنند تا اندازهگیریها را دقیقتر انجام دهند، مواد را با دقت ترکیب کنند، پدیدهها را مشاهده کنند و در نهایت به نتایج قابل اعتماد دست یابند.
انواع تجهیزات آزمایشگاهی و کاربرد آنها
تجهیزات آزمایشگاهی بر اساس کاربردشان به دستههای مختلفی تقسیم میشوند که برخی از مهمترین آنها عبارتند از:
- ظروف شیشهای:
- بشر: برای مخلوط کردن و حرارت دادن مایعات استفاده میشود.
- ارلن مایر: برای تیتراسیون و حرارت دادن مایعات استفاده میشود.
- بالن ژوژه: برای تهیه محلولهای با حجم دقیق استفاده میشود.
- لوله آزمایش: برای انجام آزمایشهای کوچک مقیاس و نگهداری نمونهها استفاده میشود.
- ابزار اندازهگیری:
- پیپت: برای انتقال حجم مشخصی از مایع استفاده میشود.
- بورت: برای تیتراسیون و افزودن حجم دقیقی از یک مایع به محلول دیگر استفاده میشود.
- استوانه مدرج: برای اندازهگیری حجم مایعات استفاده میشود.
- ابزار گرمایشی:
- بن ماری: برای گرم کردن ملایم نمونهها استفاده میشود.
- هیتر: برای حرارت دادن مستقیم نمونهها استفاده میشود.
- آون: برای خشک کردن و استریل کردن ظروف و مواد استفاده میشود.
- ابزار جداسازی:
- قیف بوخنر: برای جداسازی جامدات از مایعات با استفاده از خلاء استفاده میشود.
- دستگاه سانتریفیوژ: برای جداسازی ذرات جامد از مایعات بر اساس چگالی آنها استفاده میشود.
- ابزار عمومی:
- همزن مغناطیسی: برای هم زدن محلولها استفاده میشود.
- اسپاتول: برای انتقال مواد جامد استفاده میشود.
- پنس: برای برداشتن اجسام کوچک استفاده میشود.

تجهیزات پیشرفته آزمایشگاهی
علاوه بر تجهیزات عمومی، آزمایشگاههای مدرن به تجهیزات پیشرفتهتری مانند:
- میکروسکوپها: برای مشاهده ساختارهای بسیار کوچک
- اسپکتروفتومترها: برای اندازهگیری جذب نور توسط نمونهها
- کروماتوگرافها: برای جداسازی و شناسایی ترکیبات مختلف در یک مخلوط
- pH متر: برای اندازهگیری pH محلولها
- دستگاههای PCR: برای تکثیر قطعات DNA
نیز مجهز هستند.
اهمیت تجهیزات آزمایشگاهی
تجهیزات آزمایشگاهی نقش بسیار مهمی در پیشرفت علم و فناوری دارند. با استفاده از این ابزارها، دانشمندان میتوانند پدیدههای طبیعی را بهتر درک کنند، داروهای جدید کشف کنند و به حل مشکلات جهانی کمک کنند.
نکات مهم در استفاده از تجهیزات آزمایشگاهی
- تمیز بودن ابزارها: قبل و بعد از استفاده از ابزارها، آنها را به خوبی تمیز کنید تا از آلودگی نمونهها جلوگیری شود.
- استفاده صحیح: هر ابزار آزمایشگاهی دارای کاربرد خاصی است. از هر ابزار برای کار مناسب خود استفاده کنید.
- کالیبراسیون: به طور مرتب ابزارهای اندازهگیری را کالیبره کنید تا دقت آنها حفظ شود.
- ایمنی: هنگام کار با ابزارهای آزمایشگاهی، نکات ایمنی را رعایت کنید و از تجهیزات ایمنی مانند دستکش و عینک استفاده کنید.

- نتیجهگیری
تجهیزات آزمایشگاهی ابزارهای ضروری برای انجام تحقیقات علمی و توسعه فناوری هستند. با انتخاب و استفاده صحیح از این ابزارها، میتوان به نتایج دقیق و قابل اعتمادی دست یافت.
تجهیزات آزمایشگاه شیمی
محصولات آزمایشگاهی ما از تولید کنندگان معتبر تهیه می شود و تضمین شده است که بالاترین استانداردهای کیفیت را رعایت می کنند. با ما خرید کنید و تجربه آزمایشگاهی خود را ارتقا دهید.
لیست تجهیزات آزمایشگاهی
تجهیزات آزمایشگاه شیمی
لیست تجهیزات آزمایشگاهی شیمی
-
شیشهآلات آزمایشگاهی:
- بشر: برای مخلوط کردن و گرم کردن مایعات استفاده میشود.
- ارلن: برای تیتراسیون و مخلوط کردن مایعات استفاده میشود.
- لوله آزمایش: برای نگهداری نمونههای کوچک و انجام واکنشهای شیمیایی استفاده میشود.
بالن: برای نگهداری و اندازهگیری دقیق حجم مایعات استفاده میشود.
- پیپت: برای انتقال حجم مشخصی از مایعات استفاده میشود.
- قیف: برای انتقال مایعات از یک ظرف به ظرف دیگر و همچنین برای صاف کردن محلولها استفاده میشود.
-
دستگاههای آزمایشگاهی:
- سانتریفیوژ: برای جداسازی ذرات با چگالیهای مختلف در یک نمونه استفاده میشود.
- اتوکلاو: برای استریل کردن تجهیزات و مواد آزمایشگاهی با استفاده از بخار آب تحت فشار و دمای بالا استفاده میشود.
- انکوباتور: برای کشت میکروارگانیسمها و سلولها در دمای ثابت و کنترل شده استفاده میشود.
- pH متر: برای اندازهگیری میزان اسیدی یا بازی بودن یک محلول استفاده میشود.
- اسپکتروفتومتر: برای اندازهگیری جذب نور توسط یک نمونه استفاده میشود و در تعیین غلظت مواد مختلف کاربرد دارد.
خرید تجهیزات آزمایشگاهی شیمی
قیمت تجهیزات آزمایشگاهی
قیمت تجهیزات آزمایشگاهی بسیار متنوع بوده و به عوامل مختلفی از جمله نوع تجهیزات، برند، مدل، کیفیت، کشور سازنده و حتی نرخ ارز بستگی دارد. بنابراین، نمیتوان یک قیمت دقیق و ثابت برای همه تجهیزات آزمایشگاهی ارائه داد.
تجهیزات آزمایشگاهی تهران
- شیشهآلات آزمایشگاهی: شامل ارلن، بشر، لوله آزمایش، پیپت، بالن و...
- دستگاههای آزمایشگاهی: سانتریفیوژ، اتوکلاو، انکوباتور، pH متر، اسپکتروفتومتر و...
- ابزارهای اندازهگیری: ترازو، خطکش، دماسنج، کرنومتر و...
- لوازم مصرفی: کاغذ صافی، نوار pH، تیوپ، نوک پیپت و...
- مواد شیمیایی: انواع اسیدها، بازها، حلالها و معرفها
نمایندگی تجهیزات آزمایشگاهی
نمایندگیهای تجهیزات آزمایشگاهی، مراکزی هستند که به عنوان واسط بین تولیدکنندگان تجهیزات آزمایشگاهی و مصرفکنندگان عمل میکنند. این نمایندگیها طیف گستردهای از تجهیزات آزمایشگاهی را از برندهای مختلف عرضه میکنند و به شما کمک میکنند تا تجهیزات مورد نیاز خود را با کیفیت بالا و قیمت مناسب تهیه کنید.







